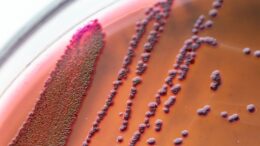

Scientists Identify Compounds That Reduce the Harmful Side Effects of Antibiotics on Gut Bacteria
Antibiotics help to fight bacterial infections, but they can also harm the helpful microbes living in the gut, which can have long-lasting health consequences. Now new research being presented at…